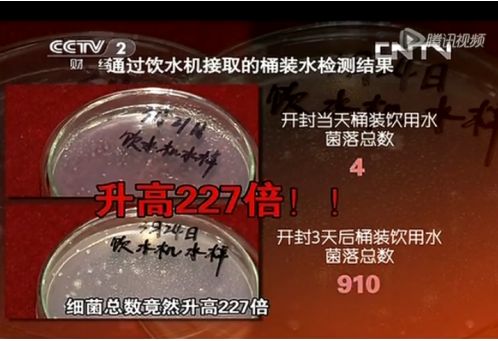

科林贝思净水,充分保障校园饮用水安全 解决开学后顾之忧
截止到目前,全国各地中小学、高等院校均已陆续开学,幼儿园包括幼托机构等也都在错峰、有序、分批次陆续开学,这给我们的校园卫生与学生健康带来了严峻的考验;虽说国内疫情基本趋稳,但未知风险依然不容忽视。
对于校园来说,学生们的健康始终是第一位的,特别是在如今的特殊形势下,孩子们的身心健康更是校园学习与生活的头等大事,其中校园饮用水安全问题就是重中之重,此前就有国外媒体报道法国巴黎水中检测出新冠病毒,让全民对水的安全问题高度警惕和关注,如何保障校园师生的饮用水安全已成为全民热议的社会焦点话题之一。
水中是否会有新冠病毒传播,我们姑且不说,我们日常饮水及用水中含有细菌等杂质有害物质却是不争的事实:
据调研,我国大部分地区校园依旧在使用桶装水,但此前CCTV-2央视财经《是真的吗》栏目做过一个实验,对比检测生产合格的桶装水开封当天和开封3天后的菌落总数,结果显示,菌落总数分别是4和910(国家标准是100),也就是说,桶装水开封3天后,菌落总数增加227倍,远远超过国家标准且达到8倍之多,学生如果长期饮用含菌量如此多的桶装水,显而易见会对身体造成很大伤害。
由此可见,如果继续使用桶装水对孩子的身体健康是有很大隐患的,安装直饮水设备成为校园饮用水安全的可靠方案。
CLBST德国科林贝思全屋净水系统中就有专门为学校、工厂等公共场所安全饮用水研发的产品,比如科林贝思CWBM-400G以及CWBM-75G两款直饮机已经在多家中小学、幼儿园内为广大师生的安全饮用水服务。

科林贝思CWBM-400G直饮机采用五级反渗透过滤系统,能有效去除水中泥沙、铁锈、余氟、重金属等有害物质;冷阴极UV杀菌灯,可高效抑菌,保护水质安全;并且热水出水温度在50-97℃,可调节,热水按键还特意设计具有安全童锁功能,能防烫伤,能充分保障校园里孩子们的饮水健康和安全。
无论是疫情期间,还是非疫情期间,校园饮用水安全问题都至关重要,孩子们都处于身体发育成长阶段,如果因饮水问题产生诸多的安全隐患,对学校、对孩子家长来说都是有很大打击的;而德国科林贝思直饮机可充分保障校园师生的饮水安全,让孩子们喝上健康安全的净水,以好的身体专心学业,让家长也放心孩子在校园的生活学习,从而可以专注工作。
科林贝思净水,守护校园饮用水安全,责无旁贷。
网址:科林贝思净水,充分保障校园饮用水安全 解决开学后顾之忧 https://www.jiaju82.com/news-view-id-708291.html

